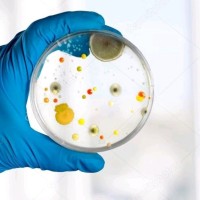
Elouiza Bennai

Company Details
- Employees
- 120
- Address
- Saint-Étienne
- Industry
- Retail Office Equipment
- NAICS
-
Office Supplies and Stationery Stores
- Website
- https://inovie.fr
- Keywords
- Aalborg Ø.
- HQ
- Saint-Étienne
Please complete the CAPTCHA to continue

Inovie is a Retail Office Equipment company. It has approximately 120 employees on record. Contact data was last refreshed in June 2026. Find Inovie's verified employee emails, phone numbers, headquarters address, and key decision makers below.

Find emails, phones & company data instantly
Your AI prospecting assistant
0 records × $0.02 per record
Secure checkout
Total price
$0.50
Enter your payment details below to complete the download. We'll email you the CSV as soon as it's ready.
Processing your payment...
Please wait while we complete your transaction
Sign in required
Create a free account or sign in to continue downloading the full results.

Sign up for a free account. No credit card required. Up to 10 free credits.

Get contact details of over 750M+ profiles across 60M companies – all with industry-leading accuracy. Sales Navigator and Recruiter users, try out our Email Finder Extension.

Find business and personal emails and mobile phone numbers with exclusive coverage across niche job titles, industries, and more for unparalleled targeting. Also available via our Contact Data API.